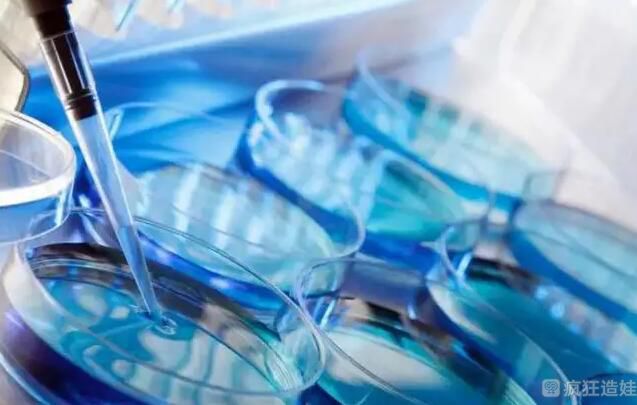

石家庄做三代试管婴儿机构排名情况?试管婴儿前如何保养卵子?
- 试管婴儿
- 2025-11-05 10:40
石家庄做三代试管婴儿机构排名情况?试管婴儿前如何保养卵子?资深人士在石家庄做体外备孕时经常会遇到这样一个问题:“因为卵巢功能下降,基础卵泡越来越少了!”“我的基础卵泡数量少是不是说明卵子质量不好?”基础卵泡数量少直接影响成功率吗?"。为了让大家知道卵泡数量少不代表卵子质量差,一起来看看吧!
在河北做一次要多少钱?要看你是选择做第一代试管婴儿,还是第二代、第。不同的试管婴儿技术,收费差别很大。同时也要看你的身体适合什么样的试管婴儿促排卵方案。不同的促排卵方案收费不同。基本上是3-10万左右。第一代试管婴儿更便宜,第三代试管婴儿价格最高。
河北医科大学第二医院,河北医科大学第四医院,石家庄妇产医院,***白求恩国际和平医院等医院都可以做试管婴儿。河北二院可以做试管婴儿,试管婴儿技术比较成熟。如果想在本地做试管婴儿,可以考虑这里。可以,河北医科大学第二医院和石家庄妇产医院都可以做第三代试管婴儿。主任医师还是副主任医师比较好,最好根据自身情况选择。
AMH是一种抗苗勒管激素,由卵巢窦和窦卵泡中的功能性颗粒细胞分泌。能真实反映卵巢的真实年龄,直接反映卵泡存量的黄金指数。而AMH与准妈妈的年龄呈负相关,会随着年龄的增长而降低。卵巢储备功能下降,这就是怀孕的准妈妈卵泡少的原因。
卵巢功能差会导致基础卵泡少,取卵少,但这并不能证明对试管婴儿成功率有决定性影响。
卵泡数量少不代表卵子质量差。通过促排卵还是可以获得优质卵子,然后制作优质胚胎进行移植和妊娠。
首先,调整你的作息时间。孕期要养成良好的习惯,晚上11点前入睡,保证8小时充足睡眠,这样才能保证孕妈妈体内激素的正常分泌。
准妈妈在日常生活中吃好饭是非常重要的。怀孕期间,准妈妈不要盲目化妆。日常饮食宜清淡,避免含糖量高的油炸食品,多吃富含雌激素的食物,如大豆、黑米、黑豆等。
现代女性的压力越来越大,工作、家庭等事情的积累,容易导致准妈妈心情不好,进而导致内分泌失调,影响卵子质量。只要准妈妈能保持良好的心情,就有助于备孕。以上就是关于石家庄做三代试管婴儿机构排名情况?试管婴儿前如何保养卵子?的全部内容。如果还有疑惑的话欢迎咨询试管婴儿资讯分享平台的专业生殖顾问。

发表评论